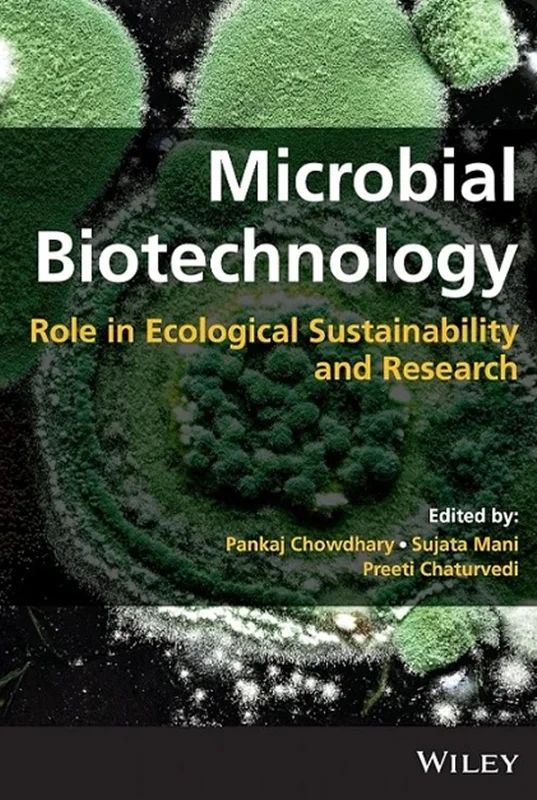

Microbial Biotechnology: Role in Ecological Sustainability and Research
Pankaj Chowdhary, Sujata Mani, Preeti Chaturvedi, B0BDPP5X3S, 1119834457, 9781119834458, 9781119834465, 9781119834472, 978-1119834458, 978-1119834465, 978-1119834472
English | 2023 | PDF | 14 MB | 477 Pages
A holistic approach covering a wide range of environmental microbial applications along with current and future trends
In Microbial Biotechnology: Role in Ecological Sustainability and Research, a team of distinguished researchers delivers an authoritative overview of the role of microbial biotechnology in the pursuit of environmental and ecological sustainability. The book provides readers with compelling presentations of microbial technology, including its applications in the removal of environmental pollutants, and sustainable agriculture using microbial biocontrol agents or bio-fertilizers.
Readers will also be able to explore the microbial reduction of greenhouse gases and a wide range of other cutting-edge applications, including the removal of various toxic environmental contaminants, such as antibiotics, pesticides, dyes, and heavy metals.
Microbial Biotechnology provides:
- A thorough introduction to microorganisms, their metabolic engineering, the human microbiome, and other foundational topics
- An in-depth exploration of environmental management, including bioremediation through a nexus approach
- A fulsome treatment of current trends in microbial biotechnology and its role in sustainable production
Perfect for professionals in applied microbiology, biotechnology, environmental engineering, green chemistry, and soil science, Microbial Biotechnology: Role in Ecological Sustainability and Research will also earn a place in the libraries of research scholars, scientists, and academicians with an interest in environmental microbiology and ecology.